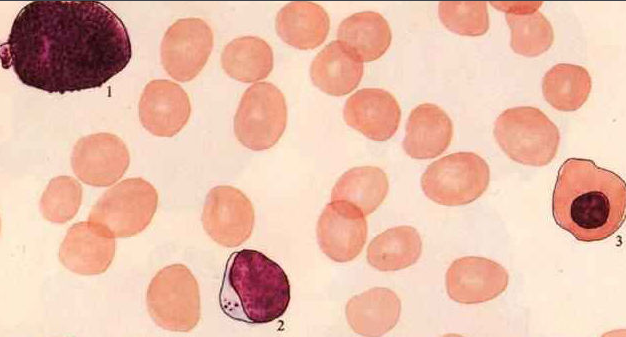

jinan hematology hospital








2023-12
急性再生障碍性贫血,相信大家对此病都不陌生。急性再障是一种非常严重的血液疾病,发病时间快,危害严重,致死率很高,所以很多人都认为此病是绝症,再无治疗可能。但是随着医学技术的不断进步,出现了许多治疗急性再障的方法,那么患者朋友最关注的肯定是哪一种方法治疗效果更好呢?接下来我们就来详细分析一下。》》》》急性再障很难治疗吗?点击询问医生
治疗急性再障的传统方法有哪些?
1、刺激造血药物:主要是雄激素。雄激素可以加强促红素细胞生成对造血干细胞的作用,促进红系定向于细胞分化为原红细胞进而增殖,成熟为红细胞。但是此方法对血小板的作用不很明显,需要较长时间才有血小板的增加。此外,这类药物对骨髓造血组织严重减少者常无效。雄激素治疗慢性再障,至少需要半年以上时间,并且难以有效治疗疾病,毒副作用很大,使患者饱受疾痛。
2、肾上腺皮质激素:肾上腺皮质激素对再生障碍性贫血患者的出血和发热效果较好。但肾上腺皮质激素的副作用较多,对粒细胞严重减少者长期使用易致严重感染,还可能引起胃肠道出血。
3、脾切除:脾切除治疗慢性再生障碍性贫血有近百年的历史。再生障碍性贫血患者切除脏后,约有1/3患者可得到缓解,但要冒较大的风险,故选择脾切除治疗再生障碍贫血应严格掌握适应证。
【医生提醒】传统的方式来治疗急性再障,存在着不少的问题,并且这些传统治疗方式不一定适合所有的患者。所以,对于治疗急性再障还需要一种科学的新型治疗体系,济南血液病医院的医生学者经过数年的临床实践研究出了中西结合的治疗体系,是广大患者朋友的福音。
中西结合治疗急性再障,对症治疗、减少反复
济南血液病医院专家团队为摒弃临床西医治疗出现的诸多弊端,在血液病临床治疗领域刻苦钻研十数载,总结出一套行之有效的“中西医结合“治疗体系”,将传统中医药与先进临床诊疗设备、技术相结合,专家会根据再障患者现有病情、自身体质结合临床精确的检查数值,制定出适合患者的治疗方案,对症治疗、减少反复。如果你也正饱受急性再障的困扰,可以拨打我们的健康热线0531-86953333或者与我们的医生进行在线的咨询,我们竭诚为您服务!
【医院地址】济南血液病医院位于天桥区小清河北路8999号。




